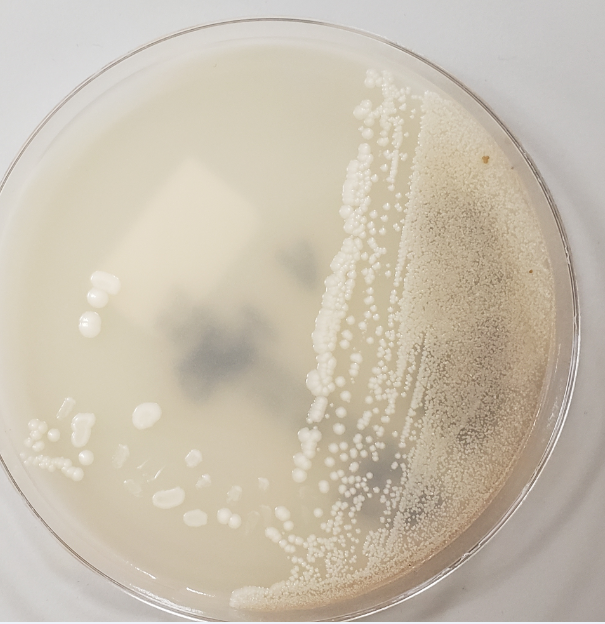

Case History
A 65 year old female with a past medical history significant for hypertension, type 2 diabetes, and asplenia, presented to a regional hospital with shortness of breath and altered mental status after the patient’s spouse found them obtunded. Emergency room workup was significant for hypoxia, acidosis, leukocytosis, and acute kidney injury with CT chest imaging showing multifocal right lung infiltrates concerning for aspiration pneumonia. The patient was started on broad spectrum antibiotics but subsequently developed increasing respiratory distress requiring intubation. The patient was transferred to our institution for further management.
Laboratory Findings
Additional testing revealed negative RSV, influenza PCR, and S. pneumoniae and Legionella urinary antigen tests. A sputum culture grew E. coli susceptible to several antibiotics and the antibiotic therapy was narrowed to doxycycline. The patient improved clinically and was transferred back to the regional hospital. Two days after transfer, one blood culture bottle which was collected upon admission to our institution (about 5 days prior), flagged positive for microbial growth. Gram stain revealed budding yeast forms, which were subsequent identified as Candida glabrata.

Discussion
Candida glabrata is a yeast which can cause infections of the bloodstream as well as urogenital tract and infections of the mucosal surfaces such as the oral cavity. Patients at increased risk for infection include immunocompromised patients, especially patients on immunosuppressant drugs, chemotherapeutic agents which cause neutropenia, and antibiotics. There has been an increasing incidence of systemic and mucosal yeast infection, thought to be due to the increasing use of immunosuppressing therapies as well as broad spectrum antibiotics. Candida species have been reported in some centers as the fourth most common cause of bloodstream infections and after Candida albicans, Candida glabrata has been reported as the second most frequent Candida species to cause nosocomial yeast infections. Candida glabrata is a significant pathogen as it can be resistant to azole antifungals, amphotericin, and echinocandins. There are several mechanisms of resistance to azoles which Candida glabrata utilizes including upregulation of genes CgCDR1 and CgCDR2 which encode drug efflux pumps. In addition, Candida glabrata also can have mutations in gene CgERG11, the usual enzymatic target of the azole antifungal drugs.
Candida glabrata appears as a budding yeast on gram stain with smooth white to cream colonies on agar plates. Microscopically, Candida glabrata appears as an oval yeast with single terminal budding. Distinguishing morphologic features of Candida glabrata include not forming pseudohypae at 37 degrees and not producing germ tubes in in vitro assays. Candida glabrata will also utilize the carbohydrate trehalose.
In some clinical cases, it is difficult to determine whether a Candida species recovered from culture represent an actual pathogen or a normal colonizer which was carried into the culture during collection. Candida species are normal commensal organisms of mucosal surfaces as well as skin, making it important to correlate clinical findings which microbial culture results. In this case, the patient had been stabilized and demonstrated great clinical improvement a few days prior to the positive blood culture result. Thus, this positive blood culture for Candida glabrata most likely represents a case where normal skin flora was inadvertently cultured.
-Liam Donnelly, MD is a 1st year anatomic and clinical pathology resident at the University of Vermont Medical Center.

-Christi Wojewoda, MD, is the Director of Clinical Microbiology at the University of Vermont Medical Center and an Associate Professor at the University of Vermont.
Aloha Dr. Donnelly and Dr. Wojewoda,
I just wanted to thank you for great clinical studies that I enjoy reading. And just wanted to let you know that there’s a typo at ‘Image 2. Wet mount from a growth plate showing yeast without speudohyphae’.
This blog, especially microbiology, has been instrumental in widening and reinforcing my knowledge in clinical settings. Thank you again.
Have a great day.
v/r
Jun
Thank you for spotting the typo–I’ve fixed it! –The Editor